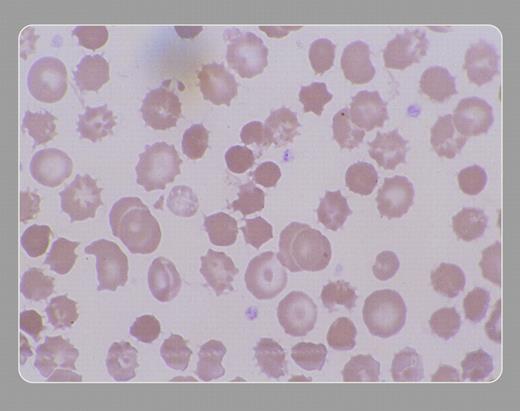
graphic

Note the acanthocytes and target cells, as well as the deeply invaginated spherocytic spur cells. The lipid abnormalities lead to the increased partitioning of free cholesterol into the red cell membrane. This results in an increase in the the surface area–volume ratio of the red cell, which produces the target cell. Further expansion of the outer leaflet of the phospholipid bilayer produces the acanthocyte, which is converted into the spur cell during circulation through the spleen.
Copyright © 2003 The American Society of Hematology
2003